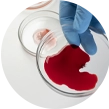
Cizumab_Hemorrhage

Product Overview
Cizumab (Bevacizumab) is a recombinant humanized monoclonal IgG1 antibody targeting vascular endothelial growth factor A (VEGF-A). It inhibits angiogenesis, thereby limiting tumor vascularization and growth.
Indications
Cizumab is indicated for use in combination with chemotherapy for:
- Metastatic colorectal cancer (mCRC)
- Non-squamous NSCLC
- Glioblastoma multiforme (GBM)
- Metastatic renal cell carcinoma (mRCC)
- Metastatic breast cancer (mBC)
- Persistent, recurrent, or metastatic cervical cancer
Mechanism of Action
Cizumab binds to VEGF-A, preventing its interaction with VEGF receptors (VEGFR-1 and VEGFR-2) on the surface of endothelial cells. This inhibition reduces microvascular growth of tumors and inhibits metastatic disease progression.
Dosage and Administration
- Administered via intravenous infusion
- Initial infusion over 90 minutes; subsequent infusions may be reduced to 60 then 30 minutes if well tolerated
- Dose varies depending on cancer type and regimen (typically 5–15 mg/kg every 2–3 weeks)
- Should not be administered as an IV push or bolus
Warnings and Precautions

Hypertension
Monitor blood pressure regularly; treat as needed

Hemorrhage
Discontinue in patients with serious bleeding

Gastrointestinal perforations
Discontinue permanently if suspected

Impaired wound healing
Hold for at least 28 days before and after surgery

Arterial thromboembolism
Risk increases in patients ≥65 years

Nephrotic syndrome
Discontinue if significant proteinuria develops

Infusion reactions
Monitor during and post-infusion
Adverse Reactions
Most common (≥10%):

Epistaxis

Hypertension

Proteinuria

Headache

Fatigue

Diarrhea

Mucocutaneous bleeding
Serious/Rare

GI perforation

Hemorrhage
(pulmonary, GI, CNS)
Wound dehiscence

PRES

CHF

Neutropenia and febrile neutropenia
(when combined with chemotherapy)Warnings and Precautions

Hypertension
Monitor blood pressure regularly; treat as needed
Hemorrhage
Discontinue in patients with serious bleeding

Gastrointestinal perforations
Discontinue permanently if suspected

Impaired wound healing
Hold for at least 28 days before and after surgery

Arterial thromboembolism
Risk increases in patients ≥65 years

Nephrotic syndrome
Discontinue if significant proteinuria develops

Infusion reactions
Monitor during and post-infusion
Adverse Reactions
Most common (≥10%):

Epistaxis

Hypertension

Proteinuria

Headache

Fatigue

Diarrhea

Mucocutaneous bleeding
Serious/Rare

GI perforation

Hemorrhage
(pulmonary, GI, CNS)
Wound dehiscence

PRES

CHF

Neutropenia and febrile neutropenia
(when combined with chemotherapy)Use in Special Populations
- Pregnancy: Category D - contraindicated
- Lactation: Discontinue breastfeeding during treatment and for 6 months after final dose
- Lipid profile: LDL-C, triglycerides, ApoB
- Pediatrics: Safety and efficacy not established
- Geriatrics: Higher incidence of arterial thromboembolic events
Storage and Stability
- Store refrigerated at 2°C to 8°C
- Protect from light
- Do not freeze or shake
Formulation & Packaging
- Available as: 100 mg/4 mL and 400 mg/16 mL single-use vials
- Dilute in 0.9% sodium chloride before administration
Please see the accompanying full Prescribing Information, including Patient Information, for Cizumab.